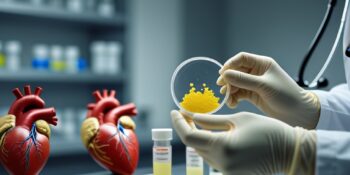

stop.edu.pl
Dostosowanie głowic termostatycznych — zapewnienie indywidualnego ogrzewania w każdej strefie

Dostosowanie głowic termostatycznych pozwala ustawić indywidualną temperaturę w każdej strefie mieszkania i umożliwia oszczędność energii rzędu 10–30%. Co to znaczy Dostosowanie głowic termostatycznych? Głowica termostatyczna to element montowany na zaworze grzejnika, który reguluje przepływ wody i tym samym moc oddawaną przez grzejnik. Dzięki nim można utworzyć ogrzewanie strefowe, czyli ustawić różne temperatury w poszczególnych pomieszczeniach — na przykład niższą w sypialni i wyższą w łazience. W praktyce oznacza to większy komfort i realne oszczędności na rachunkach za ogrzewanie, bez konieczności modernizacji kotła. Rola głowic w systemie strefowym Głowice działają jakoRead More
Żywność z pola na talerz bez opłat celnych — realna perspektywa czy mit XXI wieku?

Krótka odpowiedź: wewnątrz Unii Europejskiej handel żywnością odbywa się zasadniczo bez ceł, jednak brak ceł nie oznacza braku kosztów ani równej konkurencji. Poza UE cła, umowy preferencyjne i kontrole decydują o realnych kosztach dostępu do rynku [1][2]. Główne punkty artykułu co omówię dalej W tekście przeanalizuję strukturę łańcucha dostaw żywności, miejsca strat i koszty ukryte pod pojęciem „bez opłat celnych”, mechanizmy unijnej unii celnej i taryf zewnętrznych, różnice w kontrolach jakości oraz praktyczne wskazówki dla konsumentów i producentów. Zwrócę uwagę na dane liczbowe dotyczące Polski i Unii Europejskiej, które rzucająRead More
Co wyróżnia dobry płaszcz na zimę — solidność, dobra izolacja i klasyczny krój

Dobry płaszcz na zimę wyróżnia się trzema cechami: solidnym wykonaniem, efektywną izolacją i uniwersalnym, klasycznym krojem. Izolacja termiczna — jakie materiały i parametry wpływają na ciepło Co zapewnia najlepsze ciepło? Najlepszą relację ciepło/masa oferuje puch o sile wypełnienia 600–900 cuin oraz wełna w proporcji 80–100%. Wełna, puch i nowoczesne syntetyki stanowią trzon efektywnej izolacji. Każdy z tych materiałów ma swoje zalety: wełna oddycha i reguluje wilgoć, puch oferuje największą izolacyjność przy najmniejszej masie, a syntetyczne ociepliny zachowują właściwości izolacyjne nawet po zawilgoceniu. Dla osób aktywnych na zewnątrz warto zwrócić uwagęRead More
Zdrowy jadłospis dla serca – sposoby na ograniczenie tłuszczów trans i cukru
Osoby spożywające największe ilości tłuszczów trans miały o 50% wyższe ryzyko chorób serca, zgodnie z analizą Nurses’ Health Study, co czyni eliminację tłuszczów trans jednym z kluczowych działań prewencyjnych w profilaktyce chorób sercowo-naczyniowych. Jak tłuszcze trans uszkadzają serce podnoszą poziom cholesterolu LDL i obniżają poziom HDL, zwiększając ryzyko miażdżycy, sprzyjają tworzeniu blaszek miażdżycowych i ograniczają przepływ krwi w tętnicach, aktywizują stany zapalne w ścianie naczyń, co przyspiesza uszkodzenia naczyniowe, powiązano je również ze wzrostem ryzyka cukrzycy o około 40% przy wyższym spożyciu, co dodatkowo pogarsza profil ryzyka sercowego. Dane liczboweRead More
Tłumy dla Gry o Tron, ja wybieram domowy spokój – rozmyślania o Dubrowniku

Wybieram domowy spokój zamiast tłumów w Dubrowniku. Ten wybór to nie kaprys — to świadoma decyzja wynikająca z obserwacji, że miasto przeżywa prawdziwy kryzys z powodu masowej turystyki napędzanej popkulturą i sezonową oferą wycieczek. W artykule opisuję, dlaczego tłumy stały się problemem, jakie są konsekwencje dla mieszkańców i zabytków, oraz jak zaplanować wizytę, by cieszyć się autentycznym, spokojnym doświadczeniem. Główne punkty Dubrownik przyciąga miliony turystów, zwłaszcza po sukcesie serialu „Gra o Tron”, co prowadzi do zjawiska overtourism i presji na infrastrukturę, zabytki oraz życie codzienne mieszkańców. Miasto już wprowadziło ograniczeniaRead More
Parujące szyby — jak zmodyfikować płyn do spryskiwacza, by temu zapobiec

krótka odpowiedź: jaki skład dodać do płynu do spryskiwaczy, by ograniczyć parowanie szyb, dlaczego szyby parują — główne przyczyny i konkretne liczby, skuteczność modyfikacji płynu kontra inne metody zapobiegania parowaniu, szczegółowe receptury i proporcje modyfikacji płynu (objętościowo i procentowo), kroki przygotowania i bezpieczne stosowanie zmodyfikowanego płynu, potencjalne ryzyka: gumy wycieraczek, uszczelki, powstawanie smug, dodatkowe, skuteczne metody ograniczania parowania szyb. Krótka odpowiedź Dodaj 5–15% alkoholu izopropylowego (IPA) do gotowego płynu do spryskiwaczy — czyli około 50–150 ml IPA na 1 litr płynu — testuj mieszankę na małej powierzchni szyby i nigdyRead More
Ogrzewanie kaloryferowe czy mróz — co mocniej wysusza skórę

Krótka odpowiedź Mróz wysusza skórę szybciej i silniej, powodując ostre uszkodzenia bariery ochronnej, a ogrzewanie kaloryferowe wywołuje przewlekłe przesuszenie przez długotrwałe obniżenie wilgotności powietrza. Zarówno ekspozycja na zimny wiatr i niskie temperatury na zewnątrz, jak i suche powietrze w ogrzewanych pomieszczeniach, działają synergicznie i w sezonie zimowym znacząco zwiększają ryzyko suchości, pęknięć, rumienia i zaostrzeń chorób skórnych. Główne punkty artykułu mechanizmy przesuszania: mróz powoduje szybkie uszkodzenie bariery lipidowej, a kaloryfery prowadzą do stopniowej degradacji NMF i lipidów, konkretne liczby: skóra zimą traci nawet 2 razy więcej wody, wilgotność w domachRead More
Nawilżać czy natłuszczać skórę zimą – jak zapobiegać jej pękaniu na mrozie

Krótka odpowiedź: Zarówno nawilżać, jak i natłuszczać skórę zimą — połączenie obu działań zapobiega utracie wilgoci i pękaniu naskórka. Dlaczego skóra pęka na mrozie? niskie wilgotności powietrza na zewnątrz i w ogrzewanych pomieszczeniach powodują zwiększoną transepidermalną utratę wody (TEWL), co prowadzi do przesuszenia i kruchości naskórka, zimno i wiatr zwężają naczynia krwionośne, co ogranicza dopływ substancji odżywczych i spowalnia regenerację skóry, gorące kąpiele, ostre mydła i częste mycie rąk usuwają naturalne lipidy ochronne, a brak szybkiej odbudowy bariery lipidowej zwiększa podatność na pęknięcia, uszkodzona bariera naskórka ułatwia wnikanie drażniących substancjiRead More
Słoneczniki jako piękne i użyteczne elementy ogrodu – przewodnik do ich uprawy
Słoneczniki, z ich olśniewającymi żółtymi płatkami i potężnymi łodygami, to nie tylko kwiaty, które przyciągają wzrok, ale także fascynujące rośliny, które skrywają wiele tajemnic i właściwości. Warto zatrzymać się na chwilę, by przyjrzeć się im z bliska, dostrzegając ich niezwykłą urodę, ale także różnorodność zastosowań i korzyści, jakie przynoszą zarówno w ogrodzie, jak i w codziennym życiu. Te majestatyczne rośliny, które mogą osiągnąć imponujące rozmiary, są niczym żywe słońca, rozświetlające przestrzeń swoimi intensywnymi kolorami i radosnymi kształtami. Przyciągające uwagę piękno słoneczników Pomyśl tylko o chwili, gdy stoisz przed polem pełnymRead More
Kiedy i w jaki sposób przeprowadzać cięcie brzoskwini – kompleksowy przewodnik po pielęgnacji drzew owocowych
W cieniu rzucającym przyjemny cień, pełnym odcieni zieleni, rosną obok siebie niezwykłe drzewa, które nie tylko ozdabiają nasze ogrody, ale także obdarowują nas soczystymi owocami, które zachwycają smakiem i aromatem. Brzoskwinie, te piękne, złotawo-pomarańczowe skarby, zasługują na szczególną uwagę w kontekście ich pielęgnacji. Aby móc cieszyć się ich słodkim smakiem, niezbędne jest odpowiednie cięcie brzoskwini, które nie tylko wpływa na zdrowie i kondycję drzewa, ale także na jakość plonów, które zbierzesz. Najlepszy czas na cięcie brzoskwini Zastanawiając się nad tym, kiedy najlepiej przycinać brzoskwinie, warto zwrócić uwagę na porę roku.Read More